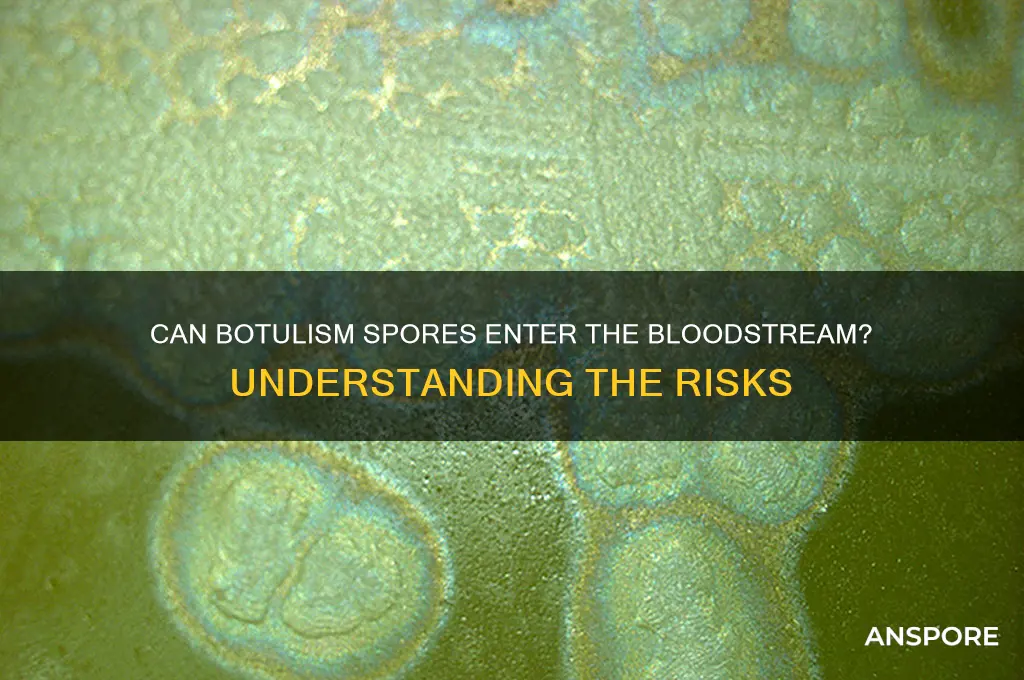
can botulism spores enter bloodstream

Botulism, a rare but potentially fatal illness caused by the toxin produced by the bacterium *Clostridium botulinum*, typically occurs through ingestion of contaminated food or wound infection. However, a critical question arises regarding whether botulism spores, the dormant form of the bacterium, can enter the bloodstream and pose a risk. While botulism spores are highly resistant to environmental conditions and can survive in soil, water, and various food products, they generally do not cause harm unless they germinate and produce the toxin. The spores themselves are not known to directly enter the bloodstream under normal circumstances, as they are usually inactivated by stomach acid or remain localized in the gastrointestinal tract. However, in rare cases, such as in individuals with compromised immune systems or those with severe wounds, there is a theoretical possibility of spore germination and toxin production, which could lead to systemic effects. Understanding the mechanisms by which botulism spores interact with the human body is essential for assessing potential risks and developing preventive measures.
| Characteristics | Values |
|---|---|
| Can Botulism Spores Enter Bloodstream? | Yes, but under specific conditions. |
| Primary Route of Entry | Spores can enter via open wounds, mucous membranes, or gastrointestinal tract. |
| Spores in Bloodstream | Spores themselves are not toxic; they must germinate into vegetative cells to produce toxin. |
| Toxin Production | Botulinum toxin is produced by vegetative cells, not spores. |
| Risk Factors for Bloodstream Entry | Open wounds, surgical sites, or compromised skin/mucous membranes. |
| Clinical Significance | Spores in bloodstream alone do not cause botulism; toxin production is required. |
| Prevention | Proper wound care, hygiene, and avoiding contaminated food/substances. |
| Treatment | Antitoxin administration if toxin is produced and symptoms appear. |
| Common Sources of Spores | Soil, dust, improperly processed food (e.g., canned goods). |
| Germination Conditions | Anaerobic environment, warmth, and nutrient availability. |
| Immune Response | Spores are generally resistant to immune system clearance until germination. |
Explore related products
$20.99 $20.99
What You'll Learn

Skin Wounds and Spores
Botulism spores, the dormant forms of *Clostridium botulinum*, are remarkably resilient, capable of surviving in soil, dust, and even canned foods. While ingestion is the most common route of infection, a lesser-known but critical pathway involves skin wounds. When these spores enter a wound, particularly in an anaerobic (oxygen-depleted) environment, they can germinate, produce toxins, and lead to wound botulism. This form of botulism is rare but severe, often associated with injection drug use, traumatic injuries, or surgical sites. Understanding how spores interact with skin wounds is essential for prevention and treatment, especially in high-risk populations.
Consider a scenario where an individual sustains a deep puncture wound while gardening in soil contaminated with botulism spores. If the wound is not properly cleaned and remains sealed, creating an oxygen-free environment, the spores can activate and multiply. The bacteria produce botulinum toxin, which enters the bloodstream, causing symptoms like muscle weakness, blurred vision, and difficulty breathing. Unlike foodborne botulism, which affects the digestive system, wound botulism targets the nervous system directly. Prompt wound care, including thorough cleaning with antiseptics and, in some cases, surgical debridement, can prevent spore germination and toxin production.
Preventing wound botulism requires vigilance, especially in environments where spores are prevalent. For instance, individuals handling soil, organic matter, or decaying materials should wear protective gloves and promptly clean any wounds with soap and water. Healthcare providers should be aware of the risk factors, particularly in patients with a history of injection drug use or recent trauma. If wound botulism is suspected, immediate medical intervention is crucial. Treatment may include antitoxin administration, wound management, and supportive care to address respiratory or neurological complications. Early recognition and action can significantly improve outcomes.
Comparing wound botulism to other forms highlights its unique challenges. Unlike foodborne botulism, which is often linked to improperly canned foods, wound botulism is localized and requires direct spore entry into a compromised site. Infant botulism, caused by spore ingestion and subsequent gut colonization, primarily affects children under one year old. Wound botulism, however, can occur in any age group, though it is more common in adults with specific risk factors. This distinction underscores the importance of tailored prevention strategies, such as educating at-risk populations and improving wound care practices in healthcare settings.
In conclusion, skin wounds provide a potential gateway for botulism spores to enter the bloodstream, leading to a severe and often overlooked form of the disease. By understanding the mechanisms of spore activation, risk factors, and preventive measures, individuals and healthcare providers can mitigate the threat of wound botulism. Practical steps, such as proper wound cleaning and awareness of high-risk environments, play a critical role in protecting against this rare but dangerous condition.
Can Black Mold Spores Penetrate and Contaminate Your Clothing?
You may want to see also

Intestinal Infections Risk
Botulism spores, though resilient in the environment, typically do not enter the bloodstream directly. Their primary threat lies in their ability to germinate and produce toxins within the intestines, particularly in conditions favorable to their growth. This intestinal colonization poses a significant risk, especially in infants and individuals with compromised gut integrity. Understanding this risk is crucial for prevention and early intervention.
Infants under one year are particularly vulnerable to intestinal botulism due to their underdeveloped gut flora and immune systems. Ingesting spores from sources like honey or contaminated soil can lead to toxin production in their intestines. Symptoms such as constipation, poor feeding, and weakness may appear within 18 to 36 hours after ingestion. Parents should avoid feeding honey to infants and ensure hygiene practices to minimize spore exposure.
Adults face a different risk profile, primarily through wound botulism or consuming improperly preserved foods. While spores themselves are harmless, they can germinate in the intestines if the environment is anaerobic and low in acid. Home-canned foods, especially those with low acidity like vegetables and meats, are common culprits. Following USDA canning guidelines, such as using pressure canners and maintaining proper pH levels, can mitigate this risk.
For individuals with gastrointestinal disorders or those taking antibiotics, the risk escalates. Antibiotics disrupt gut flora, creating conditions conducive to spore germination. Patients with conditions like inflammatory bowel disease or those undergoing gastrointestinal surgeries should monitor for symptoms like abdominal pain, nausea, and blurred vision. Probiotic supplementation, under medical supervision, may help restore gut balance and reduce susceptibility.
Prevention hinges on awareness and proactive measures. Boiling suspect foods for at least 10 minutes can destroy toxins, though spores may survive. Regularly inspecting canned goods for signs of spoilage, such as bulging lids or foul odors, is essential. For high-risk groups, avoiding raw or undercooked foods and maintaining a balanced gut microbiome are critical steps. Early recognition of symptoms and prompt medical attention can prevent severe complications, emphasizing the importance of staying informed and vigilant.
HEPA Vacuums: Effective Solution for Removing Mold Spores from Air?
You may want to see also

Injection Sites Exposure
Botulism spores, though resilient in the environment, are not typically a threat unless they germinate and produce toxins. However, injection sites present a unique vulnerability. When foreign substances are introduced directly into the bloodstream or deep tissues, the body’s natural barriers are bypassed, creating an opportunity for spores to evade immune detection. This is particularly concerning in cases of illicit drug use, where needles may be contaminated with soil or other spore-rich materials. For instance, a single contaminated injection can introduce enough spores to germinate in the anaerobic environment of muscle tissue, leading to toxin production and systemic botulism.
Consider the scenario of a 25-year-old intravenous drug user presenting with symmetric muscle weakness, blurred vision, and difficulty swallowing. These symptoms, hallmark of botulism, emerged 18–36 hours after injection. The route of exposure here is clear: spores entered the bloodstream via a contaminated needle, germinated in muscle tissue, and released botulinum toxin. This toxin then binds to nerve endings, blocking acetylcholine release and causing paralysis. The risk escalates when needles are shared or reused, as spores can survive on surfaces for extended periods.
To mitigate this risk, harm reduction strategies are critical. First, ensure all injection equipment is sterile. Needle exchange programs provide clean supplies and reduce spore contamination. Second, avoid injecting in areas with visible dirt or debris, as these are likely spore reservoirs. Third, recognize early symptoms of botulism—such as drooping eyelids or slurred speech—and seek immediate medical attention. Antitoxin administration within 24 hours of symptom onset can neutralize circulating toxins, though it cannot reverse existing nerve damage.
Comparatively, medical injections carry a lower risk due to stringent sterilization protocols. For example, botulinum toxin injections for cosmetic or therapeutic purposes use purified, lab-grown toxin, eliminating spore exposure. However, accidental contamination during compounding or administration remains a theoretical risk, underscoring the importance of aseptic technique. In contrast, non-sterile environments, such as those in recreational drug use, amplify the danger exponentially.
In conclusion, injection sites serve as a direct pathway for botulism spores to enter the bloodstream, particularly in high-risk settings. Practical steps—sterile equipment, clean injection sites, and prompt symptom recognition—can significantly reduce this risk. While medical injections are safer, any breach in sterility protocols can have severe consequences. Awareness and preventive measures are key to safeguarding against this rare but potentially fatal exposure route.
Unveiling the Fascinating World of Spores: Reproduction Secrets Explained
You may want to see also
Explore related products
$19.97 $21.99

Bloodstream Entry Mechanisms
Botulism spores, produced by the bacterium *Clostridium botulinum*, are remarkably resilient, capable of surviving extreme conditions such as heat, desiccation, and chemicals. However, their entry into the bloodstream is not a straightforward process. Unlike vegetative bacteria, spores are dormant and lack metabolic activity, making them less likely to invade tissues directly. For botulism to occur, spores must first germinate into active bacteria, which then produce the potent botulinum toxin. Understanding how these spores might enter the bloodstream is critical, as systemic toxin dissemination leads to severe, potentially fatal symptoms like muscle paralysis.
One potential mechanism for bloodstream entry involves ingestion of contaminated food or water. When botulism spores are consumed, they can survive the acidic environment of the stomach and reach the intestines. In rare cases, particularly in individuals with compromised gut integrity (e.g., due to surgery, inflammatory bowel disease, or prolonged antibiotic use), spores may germinate and produce toxin locally. If the toxin breaches the intestinal barrier—perhaps through damaged mucosa or increased permeability—it can enter the bloodstream. Infants are especially vulnerable due to their underdeveloped gastrointestinal systems, which is why honey (a potential spore source) is discouraged for children under one year old.
Another pathway involves direct inoculation of spores into tissues, bypassing the gastrointestinal tract. This can occur through contaminated wound sites, where spores germinate and produce toxin in an anaerobic environment. While the toxin itself, not the spores, is responsible for systemic effects, the wound acts as a gateway for toxin production. For instance, cases of wound botulism have been reported in injection drug users, where spores introduced via contaminated needles germinate in muscle tissue. The toxin then diffuses into the bloodstream, causing systemic symptoms. Prompt wound cleaning and antibiotic treatment are critical to prevent spore germination and toxin release.
In rare instances, bloodstream entry may occur via inhalation or ocular exposure, though these routes are less documented. Inhalation of spore-contaminated dust or aerosols could theoretically lead to germination in the respiratory tract, with toxin absorption into the bloodstream. Similarly, ocular exposure to spores, while unlikely to cause systemic botulism, highlights the importance of protective measures in laboratory or industrial settings. Practical precautions include wearing gloves, masks, and eye protection when handling materials at risk of contamination.
Understanding these mechanisms underscores the importance of prevention. Foodborne botulism can be mitigated by proper canning techniques (e.g., boiling low-acid foods for at least 10 minutes at 240°F) and avoiding consumption of bulging or foul-smelling containers. Wound care, especially for deep or punctured injuries, should include thorough cleaning and medical evaluation. For infants, strict adherence to dietary guidelines, such as avoiding honey until age one, is essential. By targeting these entry points, the risk of botulism spores reaching the bloodstream—and the toxin causing systemic harm—can be significantly reduced.
Understanding Isolated Spore Syringes: A Beginner's Guide to Mushroom Cultivation
You may want to see also

Immune System Response
Botulism spores, produced by the bacterium *Clostridium botulinum*, are remarkably resilient, capable of surviving in harsh environments, including soil, water, and improperly processed food. While ingestion of contaminated food is the most common route of infection, the question of whether these spores can enter the bloodstream directly is critical for understanding the immune system’s role in preventing systemic infection. Spores themselves are generally inert and do not cause harm unless they germinate into active bacteria, which then produce the potent botulinum toxin. However, under rare circumstances, such as in individuals with compromised skin barriers or through invasive medical procedures, spores could theoretically gain access to the bloodstream. This scenario underscores the importance of the immune system’s rapid and targeted response to neutralize potential threats before they escalate.
The immune system’s first line of defense against botulism spores involves physical and chemical barriers, such as intact skin and stomach acidity, which typically prevent spore entry into the bloodstream. If spores bypass these barriers—for instance, through open wounds or surgical incisions—innate immune cells like macrophages and neutrophils spring into action. These cells engulf and attempt to destroy the spores through phagocytosis, a process aided by antimicrobial peptides and reactive oxygen species. However, the success of this response depends on the individual’s immune competence; immunocompromised individuals, such as those with HIV or undergoing chemotherapy, face a higher risk of spore germination and toxin production. For this reason, healthcare providers must closely monitor such patients for signs of botulism, especially after exposure to high-risk environments like soil or contaminated medical equipment.
Once botulinum spores germinate and produce toxin, the immune system shifts its focus to neutralizing the toxin itself. Antibodies, primarily IgG and IgM, are produced to bind and inactivate the toxin, preventing it from reaching nerve endings and causing paralysis. In severe cases, healthcare providers may administer antitoxin therapy, which introduces preformed antibodies to accelerate toxin neutralization. This intervention is particularly crucial in infants, who are more susceptible to botulism due to their underdeveloped immune systems and higher likelihood of ingesting spores from sources like honey. Parents and caregivers should avoid feeding honey to children under 12 months of age, as it is a known source of botulism spores.
A comparative analysis of immune responses in different age groups reveals that adults generally mount a more robust antibody response to botulinum toxin than infants or the elderly. Vaccination against botulism, though not widely available for the general public, has been explored in military and high-risk populations, demonstrating the potential for prophylactic immune priming. Such vaccines work by exposing the immune system to inactivated toxin, prompting the production of memory cells that can rapidly respond to future exposures. While this approach is promising, it highlights the need for tailored immune interventions based on age, health status, and exposure risk.
In conclusion, the immune system’s response to botulism spores is a multi-layered defense mechanism, reliant on both innate and adaptive immunity. Practical steps to support this response include maintaining skin integrity, practicing proper wound care, and avoiding known sources of spores, especially in vulnerable populations. For those at high risk, staying informed about vaccination developments and seeking prompt medical attention for suspected exposure can be life-saving. Understanding these immune dynamics not only clarifies the question of spore entry into the bloodstream but also empowers individuals to take proactive measures against this potentially deadly toxin.
Vascular Plants: Exploring Reproduction via Spores and Seeds
You may want to see also
Frequently asked questions
Botulism spores themselves do not directly enter the bloodstream. They must first germinate into active bacteria, which then produce toxins that can enter the bloodstream and cause illness.
Botulism spores can enter the body through ingestion of contaminated food, inhalation of dust containing spores, or open wounds. Once inside, they can germinate and produce toxins that may enter the bloodstream.
No, botulism spores alone cannot cause illness. The toxins produced by the bacteria after spore germination are responsible for the symptoms of botulism.
It is rare for botulism spores to enter the bloodstream directly. Most cases of botulism result from ingestion of preformed toxins in contaminated food or toxin production in the gut or wounds.
Antibiotics are not effective against botulism toxins once they are in the bloodstream. Treatment typically involves antitoxins to neutralize the effects of the toxins and supportive care.

























